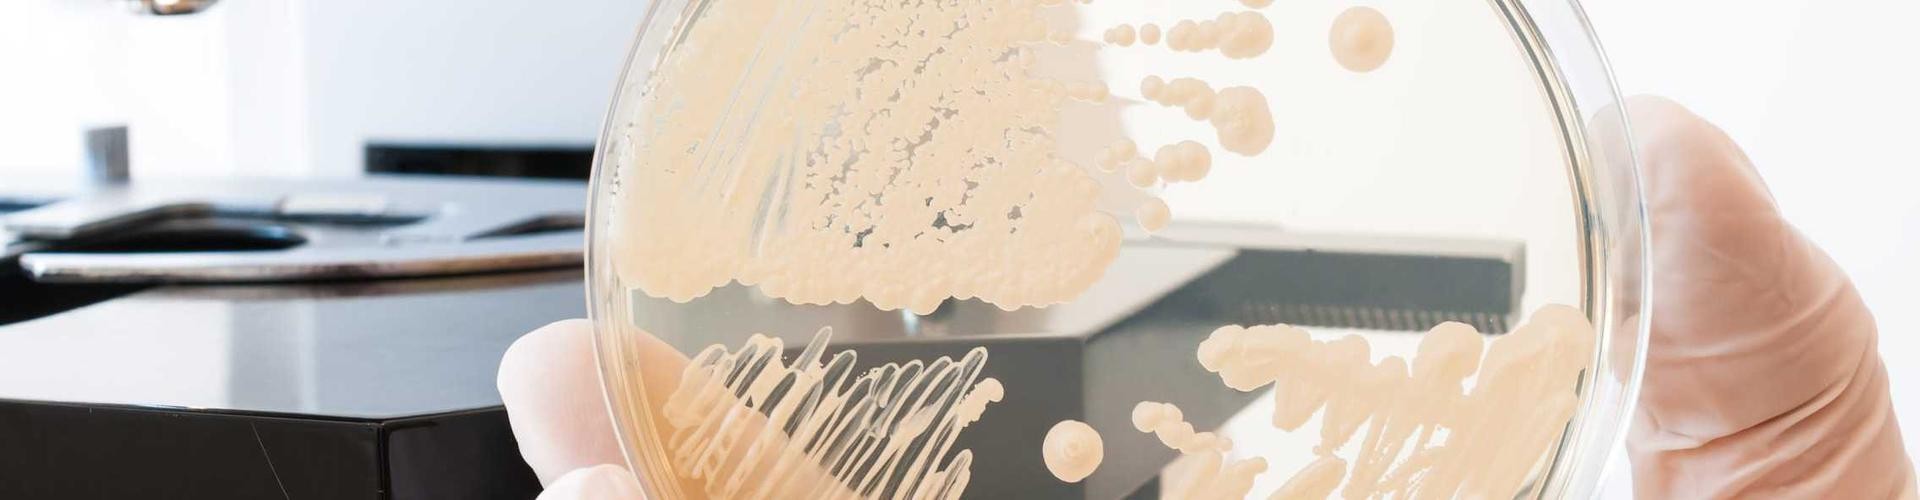

Für Ärzte und Therapeuten
Kindliches Mikrobiom und Asthma
Buttersäure als Schutzfaktor im Visier
Wachsen Kinder auf dem Bauernhof auf, entwickeln sie seltener Allergien und Asthma - das haben Bauernhof-Studien bereits vor einigen Jahren gezeigt.1 Seitdem untersuchen Wissenschaftler, wie genau die Bauernhof-Umgebung vor Allergien und Asthma schützen kann. Münchner Wissenschaftler sind jetzt im Darm von Säuglingen fündig geworden.

Wissenschaftler um Dr. Martin Depner vom Institut für Asthma- und Allergieprävention des Helmholtz Zentrums München haben untersucht, welche Rolle das Mikrobiom im Säuglingsdarm bei der Entstehung von Asthma spielt (2)
Dafür haben sie Mikrobiom-Daten analysiert, die aus der 2013 gestarteten PASTURE-Geburtskohorte stammen - einer europaweiten multizentrischen Studie mit dem Namen Protection against Allergy: Study in Rural Environments. An der PASTURE-Geburtskohorte nehmen Kinder aus ländlichen Gebieten Europas teil, von denen etwa die Hälfte auf einem familiengeführten Bauernhof aufwächst.
Reifungsmuster ist ausschlaggebend
In den österreichischen, finnischen, deutschen und schweizerischen Armen der Studie wurden bei insgesamt 930 Kindern Stuhlproben entnommen - jeweils im zweiten und zwölften Lebensmonat.
Die Wissenschaftler konnten aus den Proben interessante Erkenntnisse zur Reifung des kindlichen Mikrobioms gewinnen:
- Im Alter von zwei Monaten dominierten Bakterien der Gattung Bifidobacterium - Stillen steigerte die Zellzahlen der Bifidobakterien noch.
- Im zwölften Lebensmonat war die relative Häufigkeit der Bifidobakterien auf etwa die Hälfte zurückgegangen, während die Zellzahlen der Gattung Blautia aus der Familie der Lachnospiraceae erheblich zugenommen hatten. Auch andere Gattungen wie Coprococcus, Faecalibacterium und Roseburia waren im Alter von zwölf Monaten nachweisbar.
Neben Kindern mit diesem typischen Reifungsmuster des Darm-Mikrobioms fanden die Wissenschaftler auch eine Gruppe von Kindern, deren Mikrobiom-Zusammensetzung sowohl mit zwei Monaten, als auch mit zwölf Monaten vom typischen Reifungsmuster abwich. Die Kinder dieser Gruppe litten mit zwölf Monaten fast doppelt so häufig unter Asthma.

Je mehr Buttersäure, desto weniger Asthma
Da Bauernhof-Kinder ein reiferes Mikrobiom besitzen, das größere Mengen kurzkettiger Fettsäuren produzieren kann, analysierten Depner und Kollegen die einzelnen kurzkettigen Fettsäuren im Hinblick auf die Asthma-Entstehung. Die stärkste Assoziation fanden sie bei der Buttersäure, deren Einfluss sie in einer eingebetteten Fall-Kontroll-Studie genauer untersuchten. In der Fall-Kontroll-Studie verglichen die Wissenschaftler die Daten von 44 asthmatischen und 94 gesunden Kindern.
Das Ergebnis: Asthma trat umso seltener auf, je
- mehr Buttersäure sich im Stuhl befand.
- mehr Bakteriengruppen im Stuhl Buttersäure produzieren konnten und
- je häufiger ein Gen vorkam, das für ein wichtiges Enzym des Buttersäure-Stoffwechsels kodiert.

Auch Kaiserschnitt beeinträchtigt Mikrobiom
Bereits seit längerem ist bekannt: Kaiserschnittkinder haben ein höheres Risiko, Asthma zu entwickeln.
Wie eine aktuelle Studie4 zeigt, ist auch hier das Reifungsmuster der intestinalen Mikrobiota entscheidend. Bei Kaiserschnitt-Kindern war die Zusammensetzung der Bakteriengemeinschaft im Darm im Alter von einer Woche und einem Monat verändert - im Vergleich zu vaginal geborenen Kindern. Im Alter von einem Jahr waren die Unterschiede bei vielen Kindern kaum noch vorhanden. Allerdings gab es Kinder, bei denen die Zusammensetzung auch in dem Alter noch deutlich abwich - sie besaßen ein erhöhtes Asthmarisiko.
Candida und Rhodotorula begünstigen Allergien
Schon die Ergebnisse einer früheren Studie hatten auf die Bedeutung anti-inflammatorischer Fettsäuren im Säuglingsdarm hingewiesen: Sie fehlten im Metabolitenprofil, wenn der Darm im Alter von einem Monat mit einer allergiebegünstigenden Darm-Mikrobiota besiedelt war (3) Als allergiebegünstigend stuften die Wissenschaftler verringerte Zellzahlen der kommensalen Bakterien und erhöhte Zellzahlen der Pilz-Gattungen Candida und Rhodotorula ein. Bei den betroffenen Säuglingen war das Risiko um das bis zu Dreifache erhöht, im Alter von zwei Jahren eine Allergie zu entwickeln.
Die Wissenschaftler identifizierten bei den Säuglingen mit einer allergiebegünstigenden Mikrobiota außerdem ein Lipid, das die Gruppe von T-Zellen unterdrücken konnte, die für eine orale Toleranz relevant ist.
Hinweis auf Darm-Lungen-Achse
Nach Einschätzung von Depner und Kollegen kann das Darm-Mikrobiom über seine Stoffwechselprodukte - vor allem über die Buttersäure - zum Schutz vor Asthma beitragen. Die Wissenschaftler sehen darin auch das Konzept einer Darm-Lungen-Achse bestärkt.
